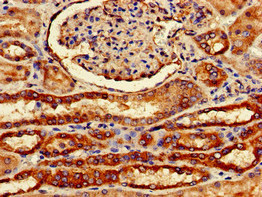
CSB-PA891570LA01HU

FZD1
FZD1,全稱Frizzled class receptor 1,也被稱為FZD1/Frizzled 1蛋白,屬于G蛋白偶聯受體Fz/Smo家族。該蛋白在多種組織中表達,包括心臟、胎盤、肺、腎臟、胰腺、前列腺和卵巢,以及胎兒肺和腎臟。FZD1蛋白在細胞信號傳導中發揮著重要作用,參與調控細胞極性、胚胎發育、神經突觸形成、細胞增殖等過程。FZD1蛋白是Wnt信號通路中的關鍵受體,能夠與Wnt蛋白結合,進而激活下游信號通路。研究表明,FZD1蛋白與多種疾病的發生發展密切相關,例如癌癥、心血管疾病、神經退行性疾病等。由于FZD1蛋白在疾病中的重要作用,它已成為藥物研發的潛在靶點。目前,針對FZD1蛋白的藥物研發主要集中在靶向Wnt信號通路異常激活的癌癥治療。例如,研究人員正在開發針對FZD1蛋白的抑制劑,以阻斷Wnt信號通路,從而抑制腫瘤細胞的生長和擴散。此外,FZD1蛋白也被用于開發針對其他疾病的藥物,例如心血管疾病和神經退行性疾病。
熱銷產品
FZD1 Antibody (CSB-PA891570LA01HU)
驗證數據

Immunohistochemistry of paraffin-embedded human prostate cancer using CSB-PA891570LA01HU at dilution of 1:100
Immunohistochemistry of paraffin-embedded human kidney tissue using CSB-PA891570LA01HU at dilution of 1:100

Immunofluorescent analysis of MCF-7 cells using CSB-PA891570LA01HU at dilution of 1:100 and Alexa Fluor 488-congugated AffiniPure Goat Anti-Rabbit IgG(H+L)
FZD1 Antibodies
FZD1 for Homo sapiens (Human)
| 產品貨號 | 產品名稱 | 種屬反應性 | 應用類型 |
|---|---|---|---|
| CSB-PA002579 | FZD1 Antibody | Human | WB, IF, ELISA |
| CSB-PA060234 | FZD1 Antibody | Human | WB, IF, ELISA |
| CSB-PA974307 | FZD1 Antibody | Human | ELISA,WB |
| CSB-PA063513 | FZD1 Antibody | Human,Mouse,Rat | ELISA,IHC |
| CSB-PA991727 | FZD1 Antibody | Human,Mouse,Rat | ELISA,IHC |
| CSB-PA891570LA01HU | FZD1 Antibody | Human | ELISA, IHC, IF |
| CSB-PA891570LB01HU | FZD1 Antibody, HRP conjugated | Human | ELISA |
| CSB-PA891570LC01HU | FZD1 Antibody, FITC conjugated | Human | |
| CSB-PA891570LD01HU | FZD1 Antibody, Biotin conjugated | Human | ELISA |
FZD1 Proteins
FZD1 Proteins for Mus musculus (Mouse)
| 產品貨號 | 產品名稱 | 來源 |
|---|---|---|
| CSB-YP009103MO1 CSB-EP009103MO1 CSB-BP009103MO1 CSB-MP009103MO1 CSB-EP009103MO1-B |
Recombinant Mouse Frizzled-1 (Fzd1), partial | Yeast E.coli Baculovirus Mammalian cell In Vivo Biotinylation in E.coli |
| CSB-CF009103MO | Recombinant Mouse Frizzled-1 (Fzd1) | in vitro E.coli expression system |
FZD1 Proteins for Gallus gallus (Chicken)
| 產品貨號 | 產品名稱 | 來源 |
|---|---|---|
| CSB-YP009103CH1 CSB-EP009103CH1 CSB-BP009103CH1 CSB-MP009103CH1 CSB-EP009103CH1-B |
Recombinant Chicken Frizzled-1 (FZD1), partial | Yeast E.coli Baculovirus Mammalian cell In Vivo Biotinylation in E.coli |
| CSB-CF009103CH | Recombinant Chicken Frizzled-1 (FZD1) | in vitro E.coli expression system |
FZD1 Proteins for Xenopus laevis (African clawed frog)
| 產品貨號 | 產品名稱 | 來源 |
|---|---|---|
| CSB-YP888253XBE1 CSB-EP888253XBE1 CSB-BP888253XBE1 CSB-MP888253XBE1 CSB-EP888253XBE1-B |
Recombinant Xenopus laevis Frizzled-1 (fzd1), partial | Yeast E.coli Baculovirus Mammalian cell In Vivo Biotinylation in E.coli |
| CSB-CF888253XBE | Recombinant Xenopus laevis Frizzled-1 (fzd1) | in vitro E.coli expression system |
FZD1 Proteins for Homo sapiens (Human)
| 產品貨號 | 產品名稱 | 來源 |
|---|---|---|
| CSB-YP891570HU1 CSB-EP891570HU1 CSB-BP891570HU1 CSB-MP891570HU1 CSB-EP891570HU1-B |
Recombinant Human Frizzled-1 (FZD1), partial | Yeast E.coli Baculovirus Mammalian cell In Vivo Biotinylation in E.coli |
| CSB-CF891570HU | Recombinant Human Frizzled-1 (FZD1) | in vitro E.coli expression system |












